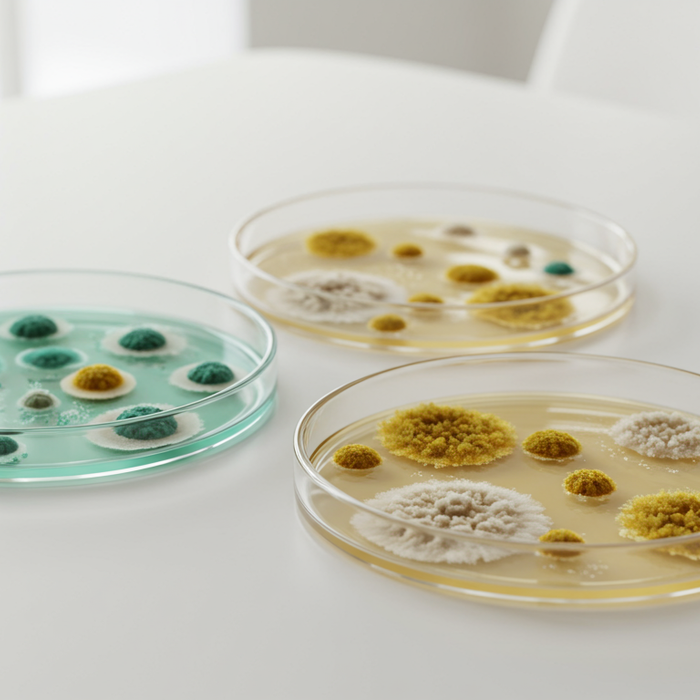
Schimmelarten: Ueberblick und Unterschiede

Ajouté à votre panier :
** total_quantity ** | ** unit_price ** / ** unit_measure **
- (-)
Sous-total du panier
À 29,00 € de la livraison gratuite!
Wichtiger Hinweis: Der Gesetzgeber fordert, dass seit dem 01.01.2025 für bestimmte Biozidprodukte ein Abgabegespräch durchgeführt werden muss. Klicke hier um das Video anzusehen. Wenn du die Videos vollständig angeschaut hast, kannst du den Bestellprozess fortführen. Diese Regelung gilt für alle Online-Shops und auch für den stationären Handel.

Du hast dir alle Info-Videos zu den Produkten im Warenkorb angeschaut. Daher kannst du direkt zur Kasse gehen. Hier kannst du dir die Videos nochmal anschauen.